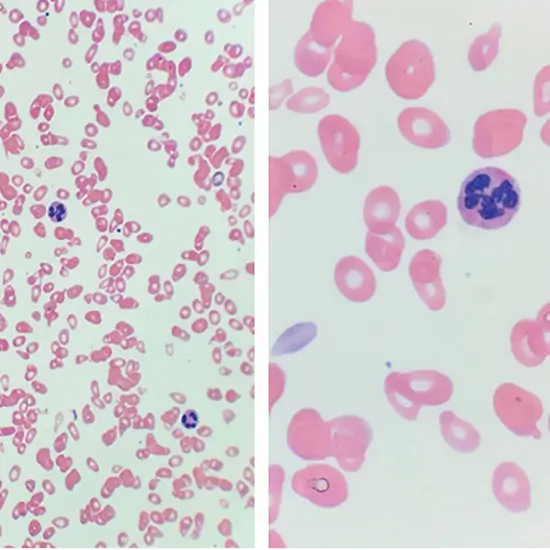

Book Macrocytic Anemia Panel Appointment Online Near me at the best price in Delhi/NCR from Ganesh Diagnostic. NABL & NABH Accredited Diagnostic centre and Pathology lab in Delhi offering a wide range of Radiology & Pathology tests. Get Free Ambulance & Free Home Sample collection. 24X7 Hour Open. Call Now at 011-47-444-444 to Book your Macrocytic Anemia Panel at 50% Discount.
Macrocytic anemia directs to macrocytosis (mean corpuscular volume (MCV) more than 100 fL) in the scene of anemia (hemoglobin minor than 12 g/dL or hematocrit (Hct) minor than 36% in nonpregnant ladies, hemoglobin minor than 11 g/dL in pregnant ladies, or hemoglobin minor than 13 g/dL or Hct minor than 41% in men). It is separated into two setups, megaloblastic (hypersegmented neutrophils) and non-megaloblastic.
The megaloblastic type is expected to impair DNA production from folate and/or vitamin B12 inadequacy, while the non-megaloblastic form happens from numerous mechanisms.
Macrocytic anemia can be separated into two main classes:
Your physician will inquire about your medical record and living patterns. They may furthermore inquire about your eating routines if they believe that you have a kind of anemia. Understanding your diet can assist them to discover if you are insufficient in iron, folate, or any of the other B vitamins.
Your physician will instruct blood examinations to inspect for anemia and broadened red blood cells. If your CBC implies anemia, your physician will accomplish a further examination named a peripheral blood smear. This examination can work to spot prematurely macrocytic or microcytic modifications in your red blood cells.
More blood examinations can also support seeing the reason for your macrocytosis and anemia. This is significant because therapy relies on the underlying reason.
While nutrient shortcomings induce most macrocytic anemias, other underlying situations may result in deficiencies.
Anemia is a situation that happens when the concentration of hemoglobin in an individual blood plunges below the normal value. A deterioration in hemoglobin is often linked with a reduction in the concentration of red blood cells (RBCs), hematocrit, and serum Iron. Hemoglobin is comprised within RBCs and is essential for the lift transport of oxygen from the lungs to the whole body and organs. Without adequate transport of oxygen, numerous signs seem in the body such as deficiency, Irritability, mental confusion, etc.
The average price for Macrocytic Anemia Panel test is seen to differ from one center to another. The price range is said to be between INR 1000 to INR 7000 in Delhi, India.
| Test Type | Macrocytic Anemia Panel |
| Includes | Macrocytic Anemia Panel Test (Physician) |
| Preparation | |
| Reporting | Within 24 hours* |
| Test Price |
₹ 1250
|

Early check ups are always better than delayed ones. Safety, precaution & care is depicted from the several health checkups. Here, we present simple & comprehensive health packages for any kind of testing to ensure the early prescribed treatment to safeguard your health.